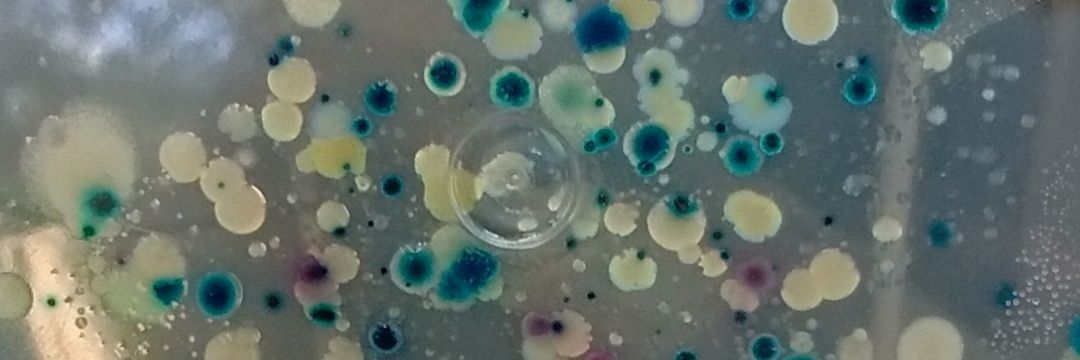
Wellington Felipe Costa banner

Wellington Felipe Costa retweetledi

wow, this is HUGE AI/science/acc
1000x scientific progress (due to AI automation) is around the corner.
"We present The AI Scientist, which creates research ideas, writes code, runs experiments, plots and analyses data, writes the entire scientific manuscript, and performs its own peer review. Its ideas, execution and presentation are of sufficient quality that the manuscript generated by this AI system passed the first round of peer review for a workshop of a top-tier machine learning conference."
This is one of the clearest signs yet that AI is moving from being a tool inside research to becoming a system that can execute a large chunk of the research process itself. The paper’s central claim is not AI can help scientists write better. It is much bigger - AI can now string together the full pipeline from concept to manuscript in an autonomous way.
this is pretty amazing
A big part of the paper is the automated reviewer. The authors say their reviewer can predict conference acceptance decisions at a level comparable to human reviewers, and they use it to score papers produced by different versions of the system.
This is a huge step toward automated "science factories", that will bring us to K1, soon after Type II civilization level, and it will happen very fast.

English